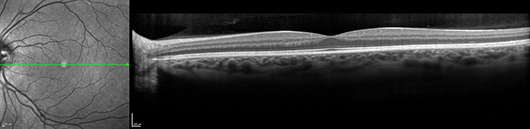
OCT of healthy macula

OCT
What is an OCT scan?
Optical Coherence Tomography (OCT) is an instrument that can be used for diagnoses and follow up of retinal and glaucoma problems. In glaucoma it is important that follow up scans are carried out to enable early detection of progression of the disease allowing early intervention and treatment.This instrument is also very sensitive in diagnosing and managing all retinal problems, such as Age Related Macular Degeneration (ARMD), pre-retinal membranes, macular holes, retinal swelling and other rarer retinal disorders.
The OCT is a non-contact medical imaging technology similar to ultrasound and MRI. With OCT, reflected light is used to produce detailed cross-sectional and 3D images of the eye.(1) These measurements are used to generate very precise cross-sectional images of the eye's anterior and posterior segment.
The examination is not painful, as contact with the eye is not required.

The OCT scan measures multiple wavelengths of reflected light across a spectrum. It acquires 40,000 A-scans per second. The increased speed and number of scans translates into higher resolution and a better chance of observing disease.
High speed image acquisition is combined with custom eye tracking technology to actively track the eye during imaging. Tracking eye movement with simultaneous dual-beam imaging minimizes motion artifact, enables noise reduction and allows the instrument to precisely track change over time. The result is point-to-point correlation between fundus and OCT scans, greater image detail and clarity, and is able assess small changes.
The different views help redefine diagnosis and treatment of many major eye diseases.